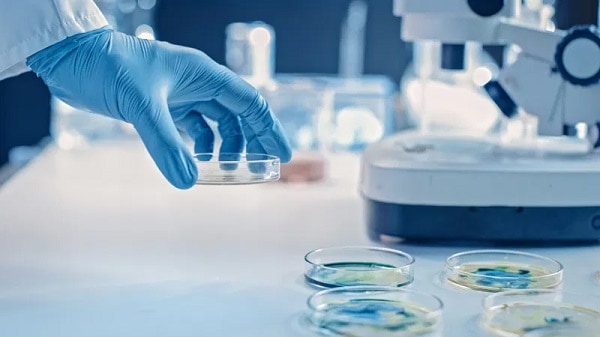

«Θεραπευτική» διακοπή κυήσεως… Μπορεί άραγε ποτέ να «θεραπεύσει» μια έκτρωση;
27 Ιουλίου 2021
Τις τελευταίες ημέρες γίναμε μάρτυρες του φυλλαδίου της Ιεράς Συνόδου που σχετίζεται με την παρότρυνση των πιστών για εμβολιασμό. Ανεξαρτήτως ιδεολογίας υπέρ ή κατά του εμβολιασμού, μας προκάλεσε βαθύτατη θλίψη και ιερή αγανάκτηση η αναφορά και μάλιστα η απενοχοποίηση της διακοπής κύησης, δηλαδή...